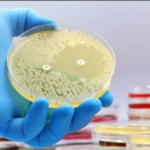

NeoActus – Quoi de neuf en IA ? – Décembre 2023
NeoActus – Quoi de neuf en IA ? – Décembre 2023
Chaque mois, nous vous proposons un article récapitulatif présentant différentes actualités liées à l’Intelligence Artificielle. S’ils n’ont pas vocation à viser l’exhaustivité, ils regroupent toutefois les actualités qui nous ont le plus marqué.
06/12 –Découverte de Gemini : Interagir avec l’IA multimodale 🌐
Google DeepMind présente Gemini, son modèle d’IA le plus performant et général à ce jour, conçu pour être multimodal et flexible. Gemini Ultra surpasse les experts humains dans la compréhension multitâche du langage et excelle dans des tâches multimodales, illustrant son potentiel révolutionnaire.

20/12 – Microsoft Copilot sait désormais créer de la musique !🎶
Microsoft vient d’annoncer un partenariat avec l’entreprise Suno pour intégrer son intelligence artificielle à Copilot via un plugin. Désormais, le chatbot de Microsoft pourra créer une chanson sur demande. Pour une fois, cette fonctionnalité est déjà disponible en France.

18/12 – Une intelligence artificielle peut détecter l’autisme chez l’enfant en analysant des photos des rétines !👁️
Des chercheurs coréens ont réussi à entraîner une intelligence artificielle à reconnaître l’autisme chez les enfants rien qu’en se basant sur des photos rétiniennes. Leur modèle serait un bon indicateur pour la sévérité des symptômes, et obtiendrait un score parfait pour le diagnostic de l’autisme…

02/01 – Le président Macron fait le vœu d’avoir 10 ans d’avance sur l’IA en 2027✅
Lors de ses vœux 2024, le président de la république a tracé la route d’un réarmement économique de la France. Et cela passera cette année par des grands chantiers de pointe, dont celui de l’intelligence artificielle.

21/12 – Une IA découvre les premiers nouveaux antibiotiques depuis plus de 60 ans 📈
Une nouvelle classe d’antibiotiques pour les bactéries « Staphylococcus aureus » résistantes aux médicaments (SARM) a été découverte en utilisant des modèles d’apprentissage profond plus transparents.